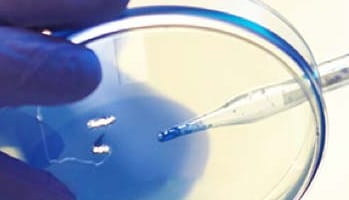

Discover some common early symptoms and signs of Alzheimer's dementia
Preliminary results suggest reversing symptoms may be possible

Getting ready to face a new year while facing cancer is no easy task
Clinical research is the study of health and illness in people. Clinical research is how we develop new treatments and gather knowledge for better health and medical care. A clinical trial is a research study involving human participants.
Search this site for IQVIA-managed clinical trials. Also, download questions to ask when you first contact a trial doctor to inquire about a clinical trial.
Lorem ipsum dolor sit amet, consectetur adipiscing elit.Lorem ipsum dolor sit amet, consectetur adipiscing elit.Lorem ipsum dolor sit amet, consectetur adipiscing elit.